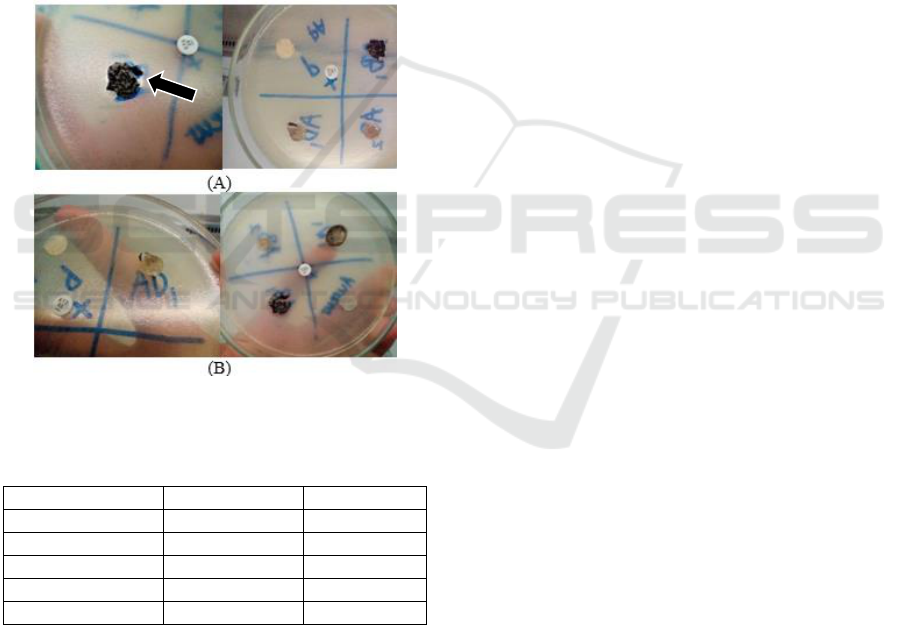

Isolation and Identification of Acanthus ilicifolius-Associated Fungi
and Investigation of Their Antibacterial Activity
Farras Daffa Imtiyaz
1
, Ferisa Lestari Nugrahayu
1
, Kawidian Putri Bayu Alam
2
, Insan Shiddiq
1
and
Hermin Pancasakti Kusumaningrum
1
1
Department of Biology, Faculty of Science and Mathematics, Diponegoro University, Semarang, Indonesia
2
Faculty of Public Health, Diponegoro University, Semarang, Indonesia
Keywords: Acanthus ilicifolius-Associated Fungi, Antibacterial, Bioactive compounds, Biopharmaceutical
Abstract: Antibacterial resistance is one of the biggest threats to the global health security today. Therefore, there is
an urgency to find alternative treatment to combat the bacteria. This paper aimed to identify and assess the
biological activity of Acanthus ilicifolius endophytic fungi, a medicinal plant originated from Asia used in
ancient medicine. In this experiment, two strains of bacterial were used, namely Staphylococcus aureus and
Pseudomonas aeruginosa. The tree samples were obtained from Jepara, Indonesia. Surface sterilization and
purification were applied to isolate the fungal. Moreover, their antibacterial ability was tested using agar
plug diffusion method. The study found that three isolates were broadly active against two types of
pathogenic bacteria; one of them was AB1-isolate. In the identification of the colony, AB1-fungal have both
black stain in the basal part and the outside layer, with rough structure and planted strongly to the basal
medium. The other fungal isolates, namely AD1 and AB2, showed a bacteriostatic effect against bacterial
test as well. Our results suggested that AB1-isolate, obtained from the stems, shows a good prospect to be a
pharmaceutical candidate to inhibit bacterial growth that normally present in the infection cases.
1 INTRODUCTION
Endophyte associates each other with the host plant
to protect them from pathogens (Vasundhara et al.,
2016); and the majorities are fungi (Strobel and
Daisy, 2003). Endophytic fungi belong to mitosporic
and meiosporic ascomycetes that reside beneath the
epidermal cell layer without causing damages. These
microorganisms are important sources of natural
products with pharmaceutical potential (Porras-
Alvaro and Bayman, 2011). They contain more than
40% of new chemical compounds from
microorganisms (Sieber and Marahiel, 2005) and
have wide-ranging applications (Zhao et al., 2011).
Acanthus ilicifolius is a type of mangrove plant
in Central Java, Indonesia, used as a traditional
medicine due to their abilities. Moreover, the plant
has anti-inflammatory, antioxidant and antimicrobial
activities. Those abilities are affected by
microorganisms beneath the plant tissues (Faeth and
Fagan, 2002). Since the plants are directly exploited,
the wild A. ilicifolius will quickly decrease,
therefore, the preferred technique to take the plant’s
pharmacological abilities is by exploring its fungal
endophyte beneath the tissues. Fungal can be grown
in the laboratory, enable us to utilize them without
exploiting the plant directly. In this paper, we were
exploring all the endophytic fungi ability to combat
two bacteria.
2 METHODS
2.1 Sample Area and Process of
Collecting
Acanthus ilicifolius samples were collected from the
growing areas named Mecok. The area is exposed to
ocean spray, mists and tides along Teluk Awur
coast, Jepara, Indonesia (S 6°37′7.86′′, W
110°38′41.16′′). Plant species found in the ground
were preferentially selected. Multiple numbers of
samples (n = 20) from Acanthus ilicifolius, locally
recognized as jeruju, were washed using tap running
water to remove the dust and dirt. Samples were
484
Imtiyaz, F., Nugrahayu, F., Alam, K., Shiddiq, I. and Sari, H.
Isolation and Identification of Acanthus ilicifolius-Associated Fungi and Investigation of Their Antibacterial Activity.
DOI: 10.5220/0007545504840488
In Proceedings of the 2nd International Conference Postgraduate School (ICPS 2018), pages 484-488
ISBN: 978-989-758-348-3
Copyright
c
2018 by SCITEPRESS – Science and Technology Publications, Lda. All rights reserved

stored in the airless polythene bags within a cooler
bag until processing.
Figure 1: Map of the sampling area
2.2 Isolation and Identification
Endophytic fungi were isolated as described
previously (Ezra et al., 2004) with minor
modification. After sampling, samples were rinsed
by tap water to remove soil or dust in a beaker glass
containing distilled water. Stems, roots and leaves
surface were sterilized and impregnated by 90%
ethanol for 1 minute, 5% sodium hypochlorite for 1
minute, sterile double distilled water (DDW) for 1
minute, 70% ethanol for 1 minute, and a quick rinse
in sterile DDW. The Potato Dextrose Agar (PDA)
media (Becton, Dickinson & Co; Sparks, MD) was
diluted by seawater in the Erlenmeyer glass. The
media was autoclaved at 121
O
C for 15 minutes, and
then mixed with 50 mg of Chloramphenicol in order
to suppress the epiphyte bacteria.
The outer tissues of the plant samples were
removed after drying the tissues under sterile
laminar airflow and passing through the flame. The
internal tissues were cut into pieces of 0.5 inch and
plated on petri dishes containing PDA media that
had been made. Each petri dish was divided into
four segments, with each segment containing plant
samples from the same organ. The plates were
sealed and incubated at room temperature and
examined for emerging fungi every 2 - 3 days. As
fungi emerged, they were transferred to the new
PDA plates.
The fungi were identified based on
characteristics according to the methods described
by Kong and Qi (1985). Colony descriptions were
based on observations on PDA under ambient
daylight conditions after 4–7 days of incubation.
Identification was performed according to the
taxonomic key, including colony diameter, texture
and colour.
2.3 Agar Plug Diffusion Method
Strains of bacteria species used to test antibacterial
activity of isolated fungi were Staphylococcus
aureus and Pseudomonas aeruginosa. These
bacterial strains were taken from Kariyadi Hospital,
Indonesia. The bacterial inoculum was prepared by
mixing a few bacterial colonies (1 mL) with 9 mL of
sterile 1.5 % NaCl and compared the turbidity with
the standard 0.5 McFarland solution. The sterile
swab was dipped properly into the mix solutions to
adjust the inoculum. In order to decrease the liquid,
the swab was pressed with gentle rotation to the
inner surface of the test tube. To obtain a perfect
growth, the entire Muller Hinton Agar (MHA)
media (Merck) surface was swabbed uniformly. The
inoculated plates were stored at room temperature
for 3-5 minutes.
The antibacterial test used agar plug diffusion
method proposed by Elleuch et al. (2010). In this
method, the fungal inoculum was prepared as that of
disc diffusion method. The fungal mycelia were
cultured in PDA for 7 days at temperature of 30
o
C.
After the fungal growth, the wells were prepared on
the plate by using sterile corks borer. The agar plugs
were transferred carefully to MHA media which
were already cultivated by bacterial test and allowed
to diffuse for 2 hours. The cultures were incubated at
37
o
C for 24-48 hours, and the plate was examined
for the presence of inhibition zones next to the
fungal plugs. After 24 hours of incubation, the
inhibition zone around each well was recorded.
3 RESULTS
Twelve segments from three parts of the plant were
used to obtain the endophyte. A total of eight fungi
isolates were obtained in the first screening, but only
four isolates were successfully re-cultivated. The
sampling type and the total number of isolates are
summarized in Table 1. Those fungi belong to four
genera of filamentous fungi. They are Fusarium sp.
(Putih), Ulocladium sp. (AB1), Cylindrocarpon sp.
(AD1), and Acremonium sp. (AB2).
Table 1: Quantity of fungi obtained from different part.
Sampling Types
Segments
Isolates
Leaves
4
1
Roots
4
1
Stems
4
1
Isolation and Identification of Acanthus ilicifolius-Associated Fungi and Investigation of Their Antibacterial Activity
485
The isolated strains were cultivated in PDA for
eight days in the ambient of light. We performed
observation on aerial mycelium and substrate
mycelium, as mycelium serves as the key of fungi
identification, including the colours and the form of
it. Morphological observation revealed that both
aerial and vegetative hyphae were abundant, well
developed, and had a varied characteristics of
mycelium. The colour of aerial and substrate
mycelium of most strains varied from white to black.
Several isolated fungi inhibited at least one
bacterial test with agar plug diffusion method and
created inhibition zones (Table 2). Among the
fungal endophyte, “putih” strain did not exhibit any
inhibited zone to the bacteria in the MHA medium.
The greatest antibacterial activity was shown by
AB1 isolate.
Figure 2: Antibacterial test to (a) Staphylococcus aureus
and (b) Pseudomonas aeruginosa.
Table 2: Antibacterial activity of endophytic fungi isolates
Isolates
P. aeruginosa
S. aureus
AB2
+
+
AB1
+
+
AD1
+
-
Putih
-
-
Chloramphinacol
+
+
Notes: + = Positive and - = Negative
4 DISCUSSION
Mangrove is one of the vital ecosystems in the
world. In addition to becoming a home to various
organisms, it plays an important role as the source of
medicinal plants. The bioactive compound of
Acanthus species has been studied expansively.
However, there is still limited information regarding
endophytic fungi derived from the plant. Two
previous studies limitedly explained about the ability
of Aspergillus flavipes from Acanthus (Bai et al.,
2014) and the endophyte diversity (Ananda and
Sridhar, 2002).
In this article, four endophytic fungi derived
from A. ilicifolius plant were isolated and
investigated for their antibacterial activity. However,
only three fungi showed antibacterial activity against
the bacterial test. AD1 did not show antibacterial
activity against Staphylococcus aureus, whereas
AB1 and AB2 show antibacterial activities. The
inhibitory activities of those two fungi were higher
than the chloramphenicol as the positive control.
The fungal plugs “Putih” did not show any
antibacterial activity. This observation was also
reported in several studies, in which endophytic
fungi showed activity against bacteria (Santos et al.,
2015). The potency of the fungi is attributed to
possible contribution of the type of media and
culture condition in the biosynthesis of active
metabolites (De Siqueira et al., 2011; Dos Santos et
al., 2015). The antibacterial activity exhibited by the
A. ilicifolius endophyte can be said to be relevant
with the leaf activity against S. aureus and P.
aeruginosa (Govindasamy and Arulpriya, 2013).
Acremonium sp. in this study showed
antibacterial activity against two bacterial test. It
was relevant to the other Acremonium species
obtained from marine sediment (Samuel et al., 2011)
and Antiaris toxicaria organism (Dai et al., 2009).
They have been reported to be a source of diverse
antibacterial compounds. Efrapeptin G and RHM1,
isolated from Acremonium sp. 021172C associating
with sponge Axinella sp, was reported to have a
potent antibacterial activity (Boot et al., 2006).
Acremonium sp. endophyte of Taxus baccata was
the source of leuesnostatin A which exhibited
effectiveness against Pythium ultimum (Yu et al.,
2010). Moreover, amides of the corresponding
amino alcohols and amino aldehydes of D-allo- and
L-isoleucine of an intertidal Acremonium furcatum
can inhibit B. subtilis, S. aureus and E. coli
(Gallardo et al., 2006). Moderate inhibitory activity
against S. aureus was exhibited by the 19-O-Methyl-
pyrrocidine B, some pyridine alkaloids isolated from
Cylindrocarpon, which is an endophytic fungus of
Sapium ellipticum, with 25 μM MIC (Ramsay et al.,
2018).
Ulocladium sp. is the typical pathogenic fungi
that may be responsible for Allergic fungal sinusitis
and nasal polyposis (Kaur et al., 2010). However,
ICPS 2018 - 2nd International Conference Postgraduate School
486

the fungal compounds exhibit various abilities for
medical benefits and form the inhibitory zone
around the fungal plates. Ophiobolin T, isolated
from Ulocladium sp. associating with Everniastrum
sp., showed moderate antibacterial activity against
B. subtilis and MRSA (Wang et al., 2013).
Ulocladium botrytis from Callyspongia vaginalis
sponge produces ulocladol, a new tyrosine kinase
inhibitor and antimicrobial, to inhibit Myxilla
incrustans (Holler et al., 1999). Surprisingly, 1-
hydroxy-6-methyl-8-(hydroxyl methyl) from the
fungi has antifungal activity (Konig et al., 2005).
5 CONCLUSIONS
Marine environment is proven to provide sources of
antibacterial compounds, particularly produced by
fungi. A total of 4 endophytic fungi isolated from
Acanthus ilicifolius showed different activities
against 2 bacteria. However, in order to find the
most effective compounds, further studies are
needed to obtain comprehensive data regarding
those antibacterial activities.
REFERENCES
Ananda, K and Sridhar, KR. 2002. Diversity of endophytic
fungi in the roots of mangrove species on the west
coast of India. Can J Microbiol. 48(10): 871-78.
Bai, ZQ., Lin, X., Wang, Y., Wang, J., Zhou, X., Yang,
B., Liu, J., Yang, X., Wang, Y., and Liu, Y. 2014.
New phenyl derivatives from endophytic fungus
Aspergillus flavipes AIL8 derived of mangrove plant
Acanthus ilicifolius. Fitoterapia. 95:194-202.
Boot, CM., Tenney, K., Valeriote, FA., and Crews, P.
2006. Highly N-Methylated Linear Peptides Produced
by an Atypical Sponge-Derived Acremonium sp. J Nat
Prod. 69(1): 83-92.
Dai, H., Gan, Y., Que, D., Wu, J., Wen, Z., and Mei, W.
2009. A new cytotoxic 19-Nor-cardenolide from the
latex of Antiaris toxicaria. Molecules. 14: 3694-3699.
De Siqueira, VM., Conti, R., De Araújo, JM., and Souza-
Motta, CM. 2011. Endophytic fungi from the
medicinal plant Lippia sidoides Cham. and their
antimicrobial activity. Symbiosis. 53(2):89-95.
Dos Santos, IP., da Silva, LC., da Silva, MV., de Araújo,
JM., Cavalcanti, MS., and Lima, VL. 2015.
Antibacterial activity of endophytic fungi from leaves
of Indigofera suffruticosa Miller (Fabaceae). Front
Microbiol. 6:350.
Elleuch, L., Shaaban, M., Smaoui, S., Karray-Rebai I.,
Fourati-Ben, FL., Shaaban, KA., and Laatsch, H.
2010. Bioactive secondary metabolites from a new
terrestrial Streptomyces sp. TN262. Appl Biochem
Biotechnol. 162(2): 579–593.
Ezra, D., Hess, WH., and Strobel, GA. 2004. New
endophytic isolates of Muscodor albus, a volatile-
antibiotic-producing fungus. Microbiol. 150:4023–31.
Faeth, SH and Fagan, WF. 2002. Fungal endophytes:
common host plant symbionts but uncommon
mutualists. Integr Comp Biol. 42(2): 360–368.
Gallardo, GL., Butler, M., Gallo, ML., Rodriguez, MA.,
Eberlin, MN., and Cabrera, GM. 2006. Antimicrobial
metabolites produced by an intertidal Acremonium
furcatum. Phytochemistry. 67(21):2403–10.
Govindasamy, C and Arulpriya, M. 2013. Antimicrobial
Activity of Acanthus Ilicifolius: Skin Infection
Pathogens. Asian Pac J Trop Dis. 3(3): 180–183.
Holler, U., Konig, G., and Wright, AD. 1999. A new
tyrosine kinase inhibitor from marine isolate of
Ulocladium botrytis and new metabolites from the
marine fungi asteromyces cruciatus and varicosporina
ramulosa. Eur j org chem. 11: 2949-2955.
Kaur, R., Wadhwa, A., Gulati, A., Agrawal, A. 2010. An
unusual phaeoid fungi: Ulocladium, as a cause of
chronic allergic fungal sinusitis. Iran J Microbiol.
2(2):95-97.
Kong, H and Qi, Z. 1985. Some new records and rare taxa
of Aspergillus of China. Bulletin of Botanical
Research. 5(3):147–152.
Konig, GM., Kehraus, S., Seibert, SF., Abdel-lateff, A.,
and Muller, D. 2005. Natural Product from Marine
Organisms and Their Associated Microbes.
Chembiochem. 7(2):229-238.
Porras-Alfaro, A and Bayman, P. 2011. Hidden Fungi,
Emergent Properties: Endophytes and Microbiomes.
Annu Rev Phytopathol. 49:291–315.
Ramsay, STK., Wafo, P., Nidja, R., Lasse, VG., Simon-
Patrick, H., Tim-Oliver, K., Christoph, J., Parichat, S.,
Matthias, UK., Wenhan, L., Rainer, K., Zhen, L., and
Peter, P. 2018. Metabolites from the endophytic
fungus Cylindrocarpon sp. isolated from tropical plant
Sapium ellipticum. Fitoterapia. 128: 175–179.
Samuel, P., Prince, L., and Prabakaran, P. 2011.
Antibacterial Activity of Marine derived Fungi
Collected from South East Coast of Tamilnadu, India.
J Microbiol Biotech Res. 1(4):86-94.
Santos, IP., Silva, LCN., Silva, MV., Araújo, JM.,
Cavalcanti, MS., and Lima, VLM. 2015. Antibacterial
activity of endophytic fungi from leaves of Indigofera
suffruticosa Miller (Fabaceae). Front Microbiol.
6:350.
Sieber, SA and Marahiel, MA. 2005. Molecular
Mechanisms Underlying Nonribosomal Peptide
Synthesis: Approaches to New Antibiotics. Chem Rev.
105(2):715–738.
Strobel, G and Daisy, B. 2003. Bioprospecting for
microbial endophytes and their natural products.
Microbiol Mol Biol Rev. 67(4):491–502.
Vasundhara, M., Kumar, A., and Reddy, MS. 2016.
Molecular Approaches to Screen Bioactive
Compounds from Endophytic Fungi. Front Microbiol.
7:1774.
Isolation and Identification of Acanthus ilicifolius-Associated Fungi and Investigation of Their Antibacterial Activity
487

Wang, QX., Bao, L., Yang, XL., Liu, DL., Guo, H., Dai,
HQ., Song, FH., Zhang, LX., Guo, LD., Li, SJ., Liu,
HW. 2013. Ophiobolins P-T, five new cytotoxic and
antibacterial sesterterpenes from the endolichenic
fungus Ulocladium sp. Fitoterapia. 90:220–7.
Yu H., Zhang L., Li L., Zheng C., Guo L., Li W., Sun P.,
Qin L. 2010. Recent developments and future
prospects of antimicrobial metabolites produced
endophytes. Microbiol Res. 165(6):437-449.
Zhao, J., Shan, T., Mou, M., and Zhou, L. 2011. Plant-
derived bioactive compounds produced by endophytic
fungi. Mini Rev Med Chem. 11(2):159–168.
ICPS 2018 - 2nd International Conference Postgraduate School
488
